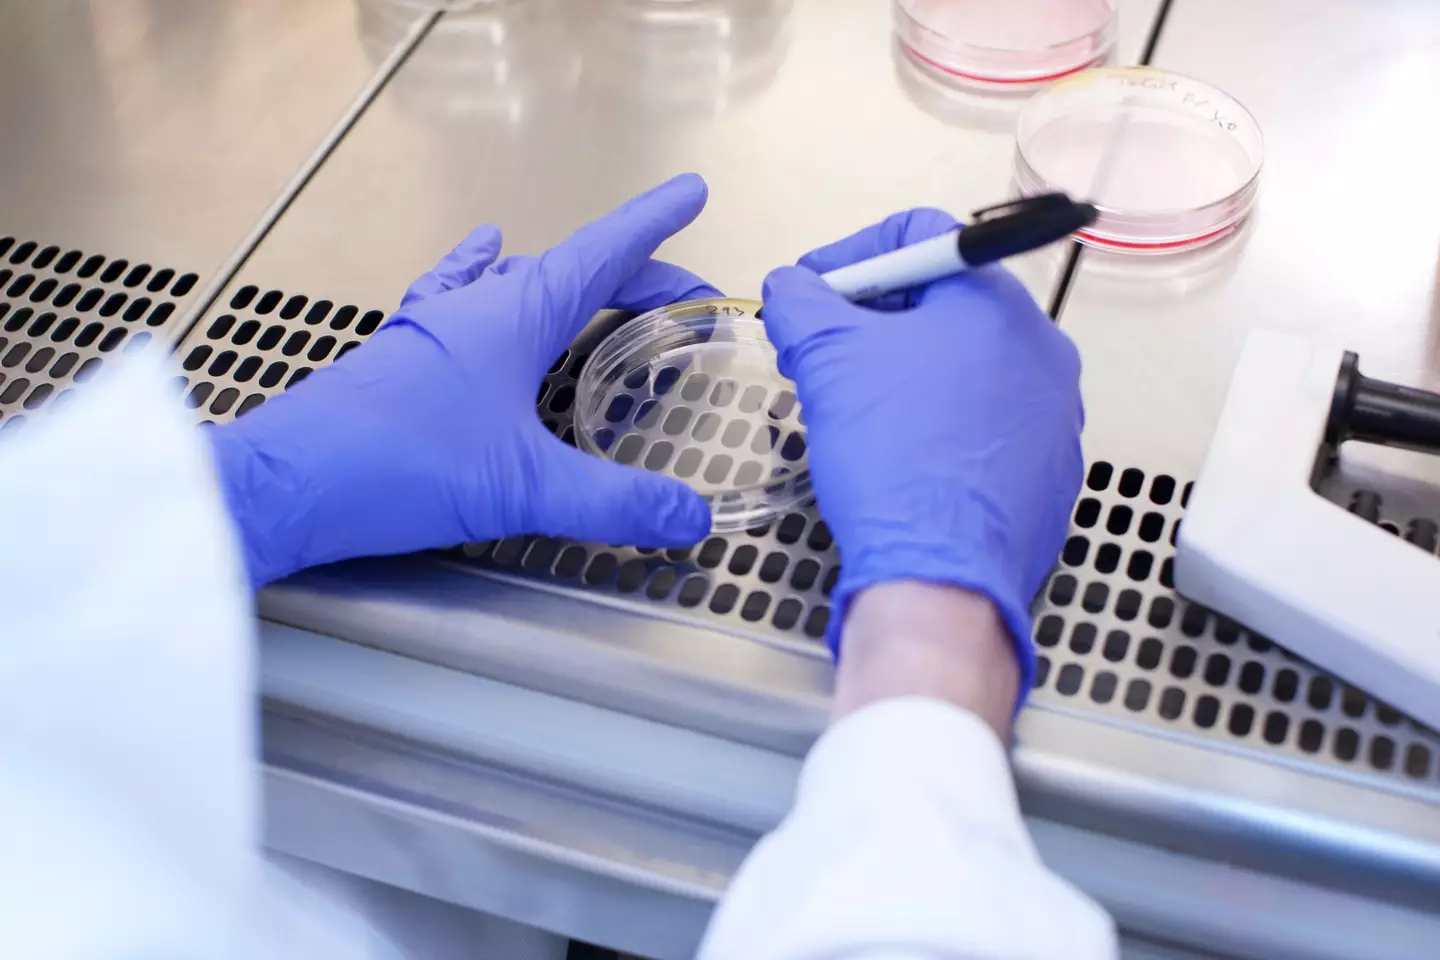

The Y chromosome is disappearing and scientists have been left divided over what exactly that could mean.
Chromosomes are one determining factor of the sex characteristics we develop - but it's believed by scientists that the Y chromosome is disintegrating over time.
Researchers have been theorising about what exactly this could mean should the Y chromosome disappear altogether - and there are a lot of different opinions.
Of course, not everyone has a Y chromosome as many people carry only XX chromosomes through their lives.
Advert

Of the two chromosomes, if it's XX or XY, the second one can determine a lot of factors around what sex characteristics a person develops.
However, the Y in XY as carried by men is the 'master switch' gene (SRY), which determines biological sex.
But the Y chromosome appears to be a bit less secure compared to the X one.
This has led scientists to carry out a study into what brought this about.
The study suggested that the Y chromosome has degenerated over the estimated 3.5 million years that humans have existed.
If this continues, they estimate that the genetic marker has roughly 4.6 million years left before it disappears from our DNA altogether.
So to be fair, it's probably not something to worry about in the short term.
This degeneration is because the Y chromosome has only one copy - passed from father to son - which has degraded over time - unlike other chromosomes that are in pairs.
So what does this mean for the Y chromosome?

While there’s no immediate cause for alarm - especially since animals don't technically need sex chromosomes - the apparent shrinking chromosome has realised some interesting questions for researchers about what could happen next.
Australian researcher, Jenny Graves, has suggested that the Y will eventually leave our DNA – possibly causing fertility problems for our species in the future – due to a lack of men.
Based at La Trobe University, she goes on to theorise that this could force the emergence of a new species as we evolve over the coming millions of years.
Other scientists have a different opinion.
Professor Darren Griffin and Peter Ellis from the University of Kent have argued that the end of the Y chromosome will not mean the end of men.
Instead, they suggest that the SRY gene will simply move to another chromosome as it has done in other species - such as the mole vole.
In fact, many genes are no longer needed for human reproduction, thanks to new treatments and genetic engineering may soon be able to replace the Y chromosome altogether.
Until then, researchers will continue to study the degrading genetic marker as they delve deeper into the heart of human biology.
Topics: News, World News, Science